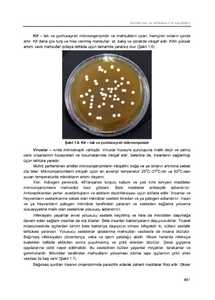

Toggle Menu
Mövzular
MODUL 1: MENYU VƏ YEMƏK RESEPTİNİN TƏRTİB EDİLMƏSİ
- GİRİŞ
- TƏLİM NƏTİCƏSİ 1: MENYUNU TƏRTİB EDİR
- 1.1. İaşə obyektinin planı və fəaliyyətini təhlil etməklə potensial bazar seqmentləri və biznes hədəflərini müəyyən edir
- 1.1.1. Bazar seqmentləri və biznes hədəflərinin müəyyən edilməsi
- 1.2. Potensial müştərilərin ehtiyaclarını müəyyən edir
- 1.2.1. Ehtiyacların müəyyən edilməsi
- 1.2.2. Müştərinin ehtiyaclarını müəyyən etmək
- 1.3. Bazar və arzuedilən biznes hədəfləri üçün müvafiq qaydada yemək menyusu hazırlayır
- 1.3.1. Yemək menyusunun hazırlanması
- 1.3.2. Menyu planının dizaynı
- 1.3.3. Menyunun yaradılması
- 1.3.4. Menyunun təqdimatı
- 1.3.5. Balanslı menyunun hazırlanması
- 1.3.6. Restoranlar üçün menyuların hazırlanma qaydası
- Sərbəst iş üçün tapşırıqlar
- Praktiki tapşırıqlar və fəaliyyətlər
- Təlim nəticələrinin qiymətləndirilməsi
- TƏLİM NƏTİCƏSİ 2: YEMƏK RESEPTİ TƏRTİB EDİR
- 2.1. Yemək növünə uyğun istifadə olunan inqrediyentlərin miqdarını müəyyən edir
- 2.1.1. İnqrediyentlərin miqdarının müəyyən edlməsi
- 2.2. Yeməyin bişirilmə üsulunu və müddətini təyin edir
- 2.2.1. Yemək bişirilmə üsulunun müəyyən edilməsi
- 2.3. Mövcud yemək reseptlərinə faydalı yeniliklər təklif edir
- 2.3.1. Yemək reseptlərində yeniliklər
- 2.3.2. Əlavə uzun zaman emal tələb etməyən məhsulları seçmək
- Sərbəst iş üçün tapşırıqlar
- Praktiki tapşırıqlar və fəaliyyətlər
- Təlim nəticələrinin qiymətləndirilməsi
MODUL 2: İNQREDİYENTLƏRİN EMAL EDİLMƏSİ
- GİRİŞ
- TƏLİM NƏTİCƏSİ 1: YEMƏK NÖVÜNƏ UYĞUN ƏT VƏ ƏT MƏHSULLARINI HAZIRLAYIR
- 1.1. Reseptə uyğun inqrediyentlərin həcmini hesablayır
- 1.2. Məhsulların (mal, dana, qoyun və dəniz məhsulları) dondurulma və donunun açılma prosesini izah edir
- 1.3. Tullantıları azaltmaqla reseptə və bişirmə formasına uyğun olaraq əti emal edir (əhatə olunanlar: sümükdən ayırmaq, çeşidlər və hissələrə bölmək, qiymə halına salmaq, duzlamaq, ədviyyatlarla qarışdırmaq və basdırmaq
- 1.4. Reseptə uyğun olaraq (mal, qoyun, dana, quş əti və dəniz məhsulları) yarımfabrikatlar hazırlayır
- Sərbəst iş üçün tapşırıqlar
- Praktiki tapşırıqlar və fəaliyyətlər
- Təlim nəticələrinin qiymətləndirilməsi
- TƏLİM NƏTİCƏSİ 2: YEMƏK NÖVÜNƏ UYĞUN TƏRƏVƏZLƏRİ HAZIRLAYIR
- 2.1. Meyvə-tərəvəzlərin ilkin hazırlıq mərhələsini nümayiş etdirir
- 2.2. Tərəvəzlərin keyfiyyət göstəricilərini müəyyən edir
- 2.3. Bişirmə formasına uyğun olaraq tərəvəzləri emal edir (əhatə olunanlar: xırdalamaq, çəkmək, sürtgəcdən keçirmək, üyütmək, əzmək, süzmək, döymək, doğramaq (sadə və mürəkkəb-dilim, dairəvi və çubuq)
- Sərbəst iş üçün tapşırıqlar
- Praktiki tapşırıqlar və fəaliyyətlər
- Təlim nəticələrinin qiymətləndirilməsi
MODUL 3: YEMƏYİN HAZIRLANMASI
- GİRİŞ
- TƏLİM NƏTİCƏSİ 1: YEMƏK NÖVÜNƏ UYĞUN İNQREDİYENTLƏRİ HAZIRLAYIR
- 1.1. Reseptə uyğun olaraq yeməyin hazırlanması üzrə tələbləri müəyyən edir
- 1.2. Reseptə uyğun inqrediyentlərin iş masasında sanitar-gigiyenik normalara uyğun toplanmasını müvafiq qaydada nümayiş etdirir
- 1.3. Reseptə uyğun olaraq inqrediyentlərin həcmini müvafiq qaydada ölçür
- 1.4. Təkrar istifadə oluna bilən qalıqları uyğun şəraitdə saxlayır
- Sərbəst iş üçün tapşırıqlar
- Praktiki tapşırıqlar və fəaliyyətlər
- Təlim nəticələrinin qiymətləndirilməsi
- TƏLİM NƏTİCƏSİ 2: RESEPTƏ UYĞUN OLARAQ YEMƏK BİŞİRİR (ƏHATƏ OLUNANLAR: ŞORBALAR; XƏMİR YEMƏKLƏRİ; ƏT, TOYUQ VƏ DƏNİZ MƏHSULLARI)
- 2.1. Reseptə, bişirmə formasına və sanitariya-gigiyena normalarına uyğun olaraq inqrediyentləri birləşdirir
- 2.2. Reseptə, sifarişə, bişirmə və təhlükəsizlik qaydalarına və sanitariya-gigiyena normalarına uyğun olaraq bişirmə üsullarını tətbiq edir (əhatə olunanlar: qaynatma, dəmləmə, buxarda bişirmə, sobada bişirmə, qızartma,
- 2.3. Yeməyin lazımi şəkildə bişirilməsinə nəzarət edir
- 2.4. Yemək və qida məhsullarının dadına baxmaqla dəqiq rəy bildirir
- 2.5. Reseptə, sifarişə və sanitariya-gigiyena normalarına uyğun olaraq yeməyə əlavə ediləcək qarnirləri bişirir
- 2.6. Xəmirin hazırlanmasını nümayiş etdirir (əhatə olunanlar: mayalı və mayasız
- 2.7. Müştərilərin haqlı şikayətləri əsasında yeməyin tərkibi, təqdim edilmə forması, həcmi və istiliyi kimi keyfiyyətlərində müvafiq dəyişikliklər edir
- Sərbəst iş üçün tapşırıqlar
- Praktiki tapşırıqlar və fəaliyyətlər
- Təlim nəticələrinin qiymətləndirilməsi
- TƏLİM NƏTİCƏSİ 3: TƏZƏ TƏRƏVƏZLƏRDƏN SALATLAR HAZIRLAYIR
- 3.1. Hazırlanma formasına və sanitariya-gigiyena normalarına uyğun olaraq tərəvəzlərdən müvafiq qaydada istifadə edir
- 3.2. Hazırlanmaya, təhlükəsizlik qaydalarına və sanitariya-gigiyena normalarına uyğun olaraq bişirmə üsullarını tətbiq edir (əhatə olunanlar: tərəvəz, mövsümi meyvələr, dənli bitkilər, xama və mayonezli, bitki yağlı).
- 3.3. Servisdən əvvəl yeməklərə/salatlara estetik görünüş verir
- Sərbəst iş üçün tapşırıqlar
- Praktiki tapşırıqlar və fəaliyyətlər
- Təlim nəticələrinin qiymətləndirilməsi
- TƏLİM NƏTİCƏSİ 4: MÜXTƏLİF MEYVƏ VƏ GİLƏMEYVƏLƏRDƏN İÇKİLƏR HAZIRLAYIR
- 4.1. Reseptə uyğun olaraq təzə, quru və konservləşdirilmiş meyvələrdən sərbəst şəkildə kompot hazırlayır
- 4.2. Reseptə uyğun olaraq giləmeyvə və müxtəlif konsistensiyalı meyvələrdən sərbəst şəkildə kisellər hazırlayır
- Sərbəst iş üçün tapşırıqlar
- Praktiki tapşırıqlar və fəaliyyətlər
- Təlim nəticələrinin qiymətləndirilməsi
MODUL 4: İAŞƏ XİDMƏTİ İŞÇİLƏRİNİN FƏALİYYƏTİNİN PLANLAŞDIRILMASI
- GİRİŞ
- TƏLİM NƏTİCƏSİ 1: İAŞƏ XİDMƏTİ İŞÇİLƏRİNİN FƏALİYYƏTİNİ PLANLAŞDIRIR
- 1.1. Müəssisədaxili qaydalara və iaşə standartlarına uyğun olaraq iaşə obyekti mətbəxinin daxili əməliyyatlara dair təlimatlarını tərtib edir
- 1.2. Müəssisədaxili prosedurlara uyğun olaraq iş növbəsini təhvil alır
- 1.3. İş növbəsindən əvvəl iaşə obyektinin işçiləri ilə iclas və hesabat görüşləri keçirməklə gündəlik planları razılaşdırır
- 1.4. Tabeliyində olan işçilər arasında vəzifə bölgüsü aparır
- 1.5. İaşə xidməti işçilərinin şəxsi qulluq və gigiyena qaydalarına əməl etmələrini nəzarətdə saxlayır
- 1.6. İaşə xidməti işçilərinin fəaliyyət planı ilə bağlı elan lövhələri, qeydiyyat jurnalları və təhvil- təslim hesabatları hazırlayır
- 1.7. Gündəlik və əlavə ehtiyaclara uyğun olaraq bazarlıq (o cümlədən, sifariş) siyahıları hazırlayır
- Sərbəst iş üçün tapşırıqlar
- Praktiki tapşırıqlar və fəaliyyətlər
- Təlim nəticələrinin qiymətləndirilməsi
- TƏLİM NƏTİCƏSİ 2: İAŞƏ XİDMƏTİ İŞÇİLƏRİNİN FƏALİYYƏTİNİ İDARƏ EDİR
- 2.1. İaşə xidməti işçilərinin effektiv fəaliyyətinə nəzarət edir
- 2.2. İaşə xidməti işçilərinin fəaliyyətini təkmilləşdirmək üçün onlara faydalı məsləhətlər verir
- 2.3. Ehtiyaca uyğun məhsulların tədarükünə nəzarət edir
- 2.4. İaşə xidmətindəki uyğunsuzluqların aradan qaldırılması üçün faydalı təkliflər verir
- 2.5. Müəssisədaxili prosedurlara uyğun olaraq iş növbəsini təhvil vermək üçün təhvil veriləcək işlərin siyahısını tutur
- Sərbəst iş üçün tapşırıqlar
- Praktiki tapşırıqlar və fəaliyyətlər
- Təlim nəticələrinin qiymətləndirilməsi
MODUL 5: MƏTBƏX AVADANLIQLARI VƏ ONLARA TEXNİKİ XİDMƏT
- GİRİŞ
- TƏLİM NƏTİCƏSİ 1: MƏTBƏX AVADANLIQLARINDAN İSTİFADƏ EDİR VƏ ONLARA TEXNİKİ XİDMƏT GÖSTƏRİR
- 1.1. Yemək hazırlama üsuluna uyğun mətbəx ləvazimatlarını müəyyən edir
- 1.2. Mətbəx ləvazimatlarının işlək vəziyyətdə və sanitar-gigiyenik normalara uyğun olmasına nəzarət edir
- 1.3. Mətbəx ləvazimatlarına istehsalçının təlimatlarına uyğun texniki qulluq qaydalarını müvafiq qaydada izah edir
- Sərbəst iş üçün tapşırıqlar
- Praktiki tapşırıqlar və fəaliyyətlər
- Təlim nəticələrinin qiymətləndirilməsi
MODUL 6: SANİTARİYA VƏ TƏHLÜKƏSİZLİK QAYDALARI
- GİRİŞ
- TƏLİM NƏTİCƏSİ 1: SANİTARİYA QAYDALARINI ANLAYIR
- 1.1. Sanitariya norma və qaydalarını izah edir
- 1.2. Daxili sanitar qaydalarını təmin edir
- 1.3. Avadanlıq, inventar və qab-qacağa qoyulan tələbləri təsvir edir
- 1.4. Qənnadı torbalarından istifadə zamanı sanitariya tələblərini izah edir
- 1.5. İşçilərin şəxsi gigiyena qaydalarını izah edir
- 1.6. Kremlə bəzədilmiş məmulatların saxlanma şəraiti və müddətini təsvir edir
- Sərbəst iş üçün tapşırıqlar
- Praktiki tapşırıqlar və fəaliyyətlər
- Təlim nəticələrinin qiymətləndirilməsi
- TƏLİM NƏTİCƏSİ 2: TƏHLÜKƏSİZLİK QAYDALARINI RİAYƏT ETMƏKLƏ FƏALİYYƏTİNİ TƏŞKİL EDİR
- 2.1. İstehsalatda təhlükəsizlik qaydalarını müvafiq qaydada izah edir
- 2.2. Alət və avadanlıqların təhlükəsizlik qaydalarına uyğun istifadəsini izah edir
- 2.3. Yanğın təhlükəsizliyi qaydalarını izah edir
- Sərbəst iş üçün tapşırıqlar
- Praktiki tapşırıqlar və fəaliyyətlər
- Təlim nəticələrinin qiymətləndirilməsi
MODUL 7: QİDA MADDƏLƏRİ VƏ QİDA ZƏHƏRLƏNMƏLƏRİ
- GİRİŞ
- TƏLİM NƏTİCƏSİ 1: QİDA MADDƏLƏRİNİN ƏHƏMIYYƏTİNİ ANLAYIR
- 1.1. İnsan həyatında qida maddələrinin əhəmiyyətini müəyyən edir
- 1.2. Qida məhsullarının kaloriliyini müəyyən edir
- 1.3. Balanslaşdırılmış qidalanma üçün məhsulların lazımi nisbətini müəyyən edir
- 1.4. Gün ərzində sərf edilən enerjinin miqdarını düzgün qaydada müəyyən edir
- Sərbəst iş üçün tapşırıqlar
- Praktiki tapşırıqlar və fəaliyyətlər
- Təlim nəticələrinin qiymətləndirilməsi
- TƏLİM NƏTİCƏSİ 2: QİDA İNFEKSİYALARINI BİLİR VƏ İŞ PROSESİNDƏ ONLARI NƏZƏRƏ ALIR
- 2.1. Qida infeksiyalarını bir-birindən ayırır
- 2.2. Qida infeksiyalarının başvermə səbəbləri və mənbəyini müəyyən edir
- 2.3. Mikroorqanizmlər və onların təbiətdə yayılma məqamlarını təsvir edir
- 2.4. Mikrobların növləri və onların morfologiya (quruluşu) və fiziologiyası (vəzifə və fəaliyyəti), insanın həyatında müsbət və mənfi rollarını izah edir
- Sərbəst iş üçün tapşırıqlar
- Praktiki tapşırıqlar və fəaliyyətlər
- Təlim nəticələrinin qiymətləndirilməsi
- TƏLİM NƏTİCƏSİ 3: QİDA ZƏHƏRLƏNMƏSİNİ ANLAYIR
- 3.1. Qida zəhərlənmələrinin növlərini fərqləndirir
- 3.2. Qida zəhərlənməsinin mənbəyi və başvermə səbəblərini müəyyən edir
- 3.3. Qida zəhərlənməsinin hər növünün əlamətləri və simptomlarını təyin edir
- Sərbəst iş üçün tapşırıqlar
- Praktiki tapşırıqlar və fəaliyyətlər
- Təlim nəticələrinin qiymətləndirilməsi
- TƏLİM NƏTİCƏSİ 4: MÜALİCƏVİ QİDALANMANI ANLAYIR VƏ TƏŞKİL EDİR
- 4.1. Pəhriz qidalanmasının növlərini sadalayır
- 4.2. Pəhriz yeməklərinin hazırlanma xüsusiyyətlərini izah edir
- 4.3. Xəstəlik və pəhrizin təyin olunmasından asılı olaraq ərzaq məhsullarından müvafiq qaydada istifadə edir
- 4.4. Müalicəvi qidalanmanın təşkil olunma qaydalarını izah edir
- 4.5. Pəhriz yeməklərinin hazırlanma xüsusiyyətlərini təsvir edir
- Sərbəst iş üçün tapşırıqlar
- Praktiki tapşırıqlar və fəaliyyətlər
- Təlim nəticələrinin qiymətləndirilməsi
- TƏLİM NƏTİCƏSİ 5: HAZIR YEMƏYİN KEYFİYYƏTİNƏ QOYULAN TƏLƏBLƏRİ MÜƏYYƏN EDİR
- 5.1. Hazırlanmış yeməyin orqanoleptik (rəngi, qoxusu, iyi, dadı, görünüşü və konsistensiyası) göstəricilərinə əsasən brakerajını aparır
- 5.2. Orqanoleptik göstəricilərə görə hazırlanmış yeməyin keyfiyyətini qiymətləndirir
- 5.3. Hazırlanmış yeməyi fiziki (refraksiya əmsalı, özlülüyü və yapışqanlılığı) göstəricilərə görə qiymətləndirir
- 5.4. Hazır yeməyin tələb olunan keyfiyyətini saxlayır
- 5.5. Hazırlanmış yeməklərdə qüsur əmələ gətirən mümkün səbəbləri aradan qaldırır
- Sərbəst iş üçün tapşırıqlar
- Praktiki tapşırıqlar və fəaliyyətlər
- Təlim nəticələrinin qiymətləndirilməsi
- Modul qiymətləndirmə meyarları
- Cavablar
- Ədəbiyyat siyahısı
Səhifələr
-
 1. səhifə
1. səhifə
-
 2. səhifə
2. səhifə
-
 3. səhifə
3. səhifə
-
 4. səhifə
4. səhifə
-
 5. səhifə
5. səhifə
-
 6. səhifə
6. səhifə
-
 7. səhifə
7. səhifə
-
 8. səhifə
8. səhifə
-
 9. səhifə
9. səhifə
-
 10. səhifə
10. səhifə
-
 11. səhifə
11. səhifə
-
 12. səhifə
12. səhifə
-
 13. səhifə
13. səhifə
-
 14. səhifə
14. səhifə
-
 15. səhifə
15. səhifə
-
 16. səhifə
16. səhifə
-
 17. səhifə
17. səhifə
-
 18. səhifə
18. səhifə
-
 19. səhifə
19. səhifə
-
 20. səhifə
20. səhifə
-
 21. səhifə
21. səhifə
-
 22. səhifə
22. səhifə
-
 23. səhifə
23. səhifə
-
 24. səhifə
24. səhifə
-
 25. səhifə
25. səhifə
-
 26. səhifə
26. səhifə
-
 27. səhifə
27. səhifə
-
 28. səhifə
28. səhifə
-
 29. səhifə
29. səhifə
-
 30. səhifə
30. səhifə
-
 31. səhifə
31. səhifə
-
 32. səhifə
32. səhifə
-
 33. səhifə
33. səhifə
-
 34. səhifə
34. səhifə
-
 35. səhifə
35. səhifə
-
 36. səhifə
36. səhifə
-
 37. səhifə
37. səhifə
-
 38. səhifə
38. səhifə
-
 39. səhifə
39. səhifə
-
 40. səhifə
40. səhifə
-
 41. səhifə
41. səhifə
-
 42. səhifə
42. səhifə
-
 43. səhifə
43. səhifə
-
 44. səhifə
44. səhifə
-
 45. səhifə
45. səhifə
-
 46. səhifə
46. səhifə
-
 47. səhifə
47. səhifə
-
 48. səhifə
48. səhifə
-
 49. səhifə
49. səhifə
-
 50. səhifə
50. səhifə
-
 51. səhifə
51. səhifə
-
 52. səhifə
52. səhifə
-
 53. səhifə
53. səhifə
-
 54. səhifə
54. səhifə
-
 55. səhifə
55. səhifə
-
 56. səhifə
56. səhifə
-
 57. səhifə
57. səhifə
-
 58. səhifə
58. səhifə
-
 59. səhifə
59. səhifə
-
 60. səhifə
60. səhifə
-
 61. səhifə
61. səhifə
-
 62. səhifə
62. səhifə
-
 63. səhifə
63. səhifə
-
 64. səhifə
64. səhifə
-
 65. səhifə
65. səhifə
-
 66. səhifə
66. səhifə
-
 67. səhifə
67. səhifə
-
 68. səhifə
68. səhifə
-
 69. səhifə
69. səhifə
-
 70. səhifə
70. səhifə
-
 71. səhifə
71. səhifə
-
 72. səhifə
72. səhifə
-
 73. səhifə
73. səhifə
-
 74. səhifə
74. səhifə
-
 75. səhifə
75. səhifə
-
 76. səhifə
76. səhifə
-
 77. səhifə
77. səhifə
-
 78. səhifə
78. səhifə
-
 79. səhifə
79. səhifə
-
 80. səhifə
80. səhifə
-
 81. səhifə
81. səhifə
-
 82. səhifə
82. səhifə
-
 83. səhifə
83. səhifə
-
 84. səhifə
84. səhifə
-
 85. səhifə
85. səhifə
-
 86. səhifə
86. səhifə
-
 87. səhifə
87. səhifə
-
 88. səhifə
88. səhifə
-
 89. səhifə
89. səhifə
-
 90. səhifə
90. səhifə
-
 91. səhifə
91. səhifə
-
 92. səhifə
92. səhifə
-
 93. səhifə
93. səhifə
-
 94. səhifə
94. səhifə
-
 95. səhifə
95. səhifə
-
 96. səhifə
96. səhifə
-
 97. səhifə
97. səhifə
-
 98. səhifə
98. səhifə
-
 99. səhifə
99. səhifə
-
 100. səhifə
100. səhifə
-
 101. səhifə
101. səhifə
-
 102. səhifə
102. səhifə
-
 103. səhifə
103. səhifə
-
 104. səhifə
104. səhifə
-
 105. səhifə
105. səhifə
-
 106. səhifə
106. səhifə
-
 107. səhifə
107. səhifə
-
 108. səhifə
108. səhifə
-
 109. səhifə
109. səhifə
-
 110. səhifə
110. səhifə
-
 111. səhifə
111. səhifə
-
 112. səhifə
112. səhifə
-
 113. səhifə
113. səhifə
-
 114. səhifə
114. səhifə
-
 115. səhifə
115. səhifə
-
 116. səhifə
116. səhifə
-
 117. səhifə
117. səhifə
-
 118. səhifə
118. səhifə
-
 119. səhifə
119. səhifə
-
 120. səhifə
120. səhifə
-
 121. səhifə
121. səhifə
-
 122. səhifə
122. səhifə
-
 123. səhifə
123. səhifə
-
 124. səhifə
124. səhifə
-
 125. səhifə
125. səhifə
-
 126. səhifə
126. səhifə
-
 127. səhifə
127. səhifə
-
 128. səhifə
128. səhifə
-
 129. səhifə
129. səhifə
-
 130. səhifə
130. səhifə
-
 131. səhifə
131. səhifə
-
 132. səhifə
132. səhifə
-
 133. səhifə
133. səhifə
-
 134. səhifə
134. səhifə
-
 135. səhifə
135. səhifə
-
 136. səhifə
136. səhifə
-
 137. səhifə
137. səhifə
-
 138. səhifə
138. səhifə
-
 139. səhifə
139. səhifə
-
 140. səhifə
140. səhifə
-
 141. səhifə
141. səhifə
-
 142. səhifə
142. səhifə
-
 143. səhifə
143. səhifə
-
 144. səhifə
144. səhifə
-
 145. səhifə
145. səhifə
-
 146. səhifə
146. səhifə
-
 147. səhifə
147. səhifə
-
 148. səhifə
148. səhifə
-
 149. səhifə
149. səhifə
-
 150. səhifə
150. səhifə
-
 151. səhifə
151. səhifə
-
 152. səhifə
152. səhifə
-
 153. səhifə
153. səhifə
-
 154. səhifə
154. səhifə
-
 155. səhifə
155. səhifə
-
 156. səhifə
156. səhifə
-
 157. səhifə
157. səhifə
-
 158. səhifə
158. səhifə
-
 159. səhifə
159. səhifə
-
 160. səhifə
160. səhifə
-
 161. səhifə
161. səhifə
-
 162. səhifə
162. səhifə
-
 163. səhifə
163. səhifə
-
 164. səhifə
164. səhifə
-
 165. səhifə
165. səhifə
-
 166. səhifə
166. səhifə
-
 167. səhifə
167. səhifə
-
 168. səhifə
168. səhifə
-
 169. səhifə
169. səhifə
-
 170. səhifə
170. səhifə
-
 171. səhifə
171. səhifə
-
 172. səhifə
172. səhifə
-
 173. səhifə
173. səhifə
-
 174. səhifə
174. səhifə
-
 175. səhifə
175. səhifə
-
 176. səhifə
176. səhifə
-
 177. səhifə
177. səhifə
-
 178. səhifə
178. səhifə
-
 179. səhifə
179. səhifə
-
 180. səhifə
180. səhifə
-
 181. səhifə
181. səhifə
-
 182. səhifə
182. səhifə
-
 183. səhifə
183. səhifə
-
 184. səhifə
184. səhifə
-
 185. səhifə
185. səhifə
-
 186. səhifə
186. səhifə
-
 187. səhifə
187. səhifə
-
 188. səhifə
188. səhifə
-
 189. səhifə
189. səhifə
-
 190. səhifə
190. səhifə
-
 191. səhifə
191. səhifə
-
 192. səhifə
192. səhifə
-
 193. səhifə
193. səhifə
-
 194. səhifə
194. səhifə
-
 195. səhifə
195. səhifə
-
 196. səhifə
196. səhifə
-
 197. səhifə
197. səhifə
-
 198. səhifə
198. səhifə
-
 199. səhifə
199. səhifə
-
 200. səhifə
200. səhifə
-
 201. səhifə
201. səhifə
-
 202. səhifə
202. səhifə
-
 203. səhifə
203. səhifə
-
 204. səhifə
204. səhifə
-
 205. səhifə
205. səhifə
-
 206. səhifə
206. səhifə
-
 207. səhifə
207. səhifə
-
 208. səhifə
208. səhifə
-
 209. səhifə
209. səhifə
-
 210. səhifə
210. səhifə
-
 211. səhifə
211. səhifə
-
 212. səhifə
212. səhifə
-
 213. səhifə
213. səhifə
-
 214. səhifə
214. səhifə
-
 215. səhifə
215. səhifə
-
 216. səhifə
216. səhifə
-
 217. səhifə
217. səhifə
-
 218. səhifə
218. səhifə
-
 219. səhifə
219. səhifə
-
 220. səhifə
220. səhifə
-
 221. səhifə
221. səhifə
-
 222. səhifə
222. səhifə
-
 223. səhifə
223. səhifə
-
 224. səhifə
224. səhifə
-
 225. səhifə
225. səhifə
-
 226. səhifə
226. səhifə
-
 227. səhifə
227. səhifə
-
 228. səhifə
228. səhifə
-
 229. səhifə
229. səhifə
-
 230. səhifə
230. səhifə
-
 231. səhifə
231. səhifə
-
 232. səhifə
232. səhifə
-
 233. səhifə
233. səhifə
-
 234. səhifə
234. səhifə
-
 235. səhifə
235. səhifə
-
 236. səhifə
236. səhifə
-
 237. səhifə
237. səhifə
-
 238. səhifə
238. səhifə
-
 239. səhifə
239. səhifə
-
 240. səhifə
240. səhifə
-
 241. səhifə
241. səhifə
-
 242. səhifə
242. səhifə
-
 243. səhifə
243. səhifə
-
 244. səhifə
244. səhifə
-
 245. səhifə
245. səhifə
-
 246. səhifə
246. səhifə
-
 247. səhifə
247. səhifə
-
 248. səhifə
248. səhifə
-
 249. səhifə
249. səhifə
-
 250. səhifə
250. səhifə
-
 251. səhifə
251. səhifə
-
 252. səhifə
252. səhifə
-
 253. səhifə
253. səhifə
-
 254. səhifə
254. səhifə
-
 255. səhifə
255. səhifə
-
 256. səhifə
256. səhifə
-
 257. səhifə
257. səhifə
-
 258. səhifə
258. səhifə
-
 259. səhifə
259. səhifə
-
 260. səhifə
260. səhifə
-
 261. səhifə
261. səhifə
-
 262. səhifə
262. səhifə
-
 263. səhifə
263. səhifə
-
 264. səhifə
264. səhifə
-
 265. səhifə
265. səhifə
-
 266. səhifə
266. səhifə
-
 267. səhifə
267. səhifə
-
 268. səhifə
268. səhifə
-
 269. səhifə
269. səhifə
-
 270. səhifə
270. səhifə
-
 271. səhifə
271. səhifə
-
 272. səhifə
272. səhifə
-
 273. səhifə
273. səhifə
-
 274. səhifə
274. səhifə
-
 275. səhifə
275. səhifə
-
 276. səhifə
276. səhifə
-
 277. səhifə
277. səhifə
-
 278. səhifə
278. səhifə
-
 279. səhifə
279. səhifə
-
 280. səhifə
280. səhifə
-
 281. səhifə
281. səhifə
-
 282. səhifə
282. səhifə
-
 283. səhifə
283. səhifə
-
 284. səhifə
284. səhifə
-
 285. səhifə
285. səhifə
-
 286. səhifə
286. səhifə
-
 287. səhifə
287. səhifə
-
 288. səhifə
288. səhifə
-
 289. səhifə
289. səhifə
-
 290. səhifə
290. səhifə
-
 291. səhifə
291. səhifə
-
 292. səhifə
292. səhifə
-
 293. səhifə
293. səhifə
-
 294. səhifə
294. səhifə
-
 295. səhifə
295. səhifə
-
 296. səhifə
296. səhifə
-
 297. səhifə
297. səhifə
-
 298. səhifə
298. səhifə
-
 299. səhifə
299. səhifə
-
 300. səhifə
300. səhifə
-
 301. səhifə
301. səhifə
-
 302. səhifə
302. səhifə
-
 303. səhifə
303. səhifə
-
 304. səhifə
304. səhifə
-
 305. səhifə
305. səhifə
-
 306. səhifə
306. səhifə
-
 307. səhifə
307. səhifə
-
 308. səhifə
308. səhifə
-
 309. səhifə
309. səhifə
-
 310. səhifə
310. səhifə
-
 311. səhifə
311. səhifə
-
 312. səhifə
312. səhifə
-
 313. səhifə
313. səhifə
-
 314. səhifə
314. səhifə
-
 315. səhifə
315. səhifə
-
 316. səhifə
316. səhifə
-
 317. səhifə
317. səhifə
-
 318. səhifə
318. səhifə
-
 319. səhifə
319. səhifə
-
 320. səhifə
320. səhifə
-
 321. səhifə
321. səhifə
-
 322. səhifə
322. səhifə
-
 323. səhifə
323. səhifə
-
 324. səhifə
324. səhifə
-
 325. səhifə
325. səhifə
-
 326. səhifə
326. səhifə
-
 327. səhifə
327. səhifə
-
 328. səhifə
328. səhifə
-
 329. səhifə
329. səhifə
-
 330. səhifə
330. səhifə
-
 331. səhifə
331. səhifə
-
 332. səhifə
332. səhifə
-
 333. səhifə
333. səhifə
-
 334. səhifə
334. səhifə
-
 335. səhifə
335. səhifə
-
 336. səhifə
336. səhifə
-
 337. səhifə
337. səhifə
-
 338. səhifə
338. səhifə
-
 339. səhifə
339. səhifə
-
 340. səhifə
340. səhifə
-
 341. səhifə
341. səhifə
-
 342. səhifə
342. səhifə
-
 343. səhifə
343. səhifə
-
 344. səhifə
344. səhifə
-
 345. səhifə
345. səhifə
-
 346. səhifə
346. səhifə
-
 347. səhifə
347. səhifə
-
 348. səhifə
348. səhifə
-
 349. səhifə
349. səhifə
-
 350. səhifə
350. səhifə
-
 351. səhifə
351. səhifə
-
 352. səhifə
352. səhifə
-
 353. səhifə
353. səhifə
-
 354. səhifə
354. səhifə
-
 355. səhifə
355. səhifə
-
 356. səhifə
356. səhifə
-
 357. səhifə
357. səhifə
-
 358. səhifə
358. səhifə
-
 359. səhifə
359. səhifə
-
 360. səhifə
360. səhifə
-
 361. səhifə
361. səhifə
-
 362. səhifə
362. səhifə
-
 363. səhifə
363. səhifə
-
 364. səhifə
364. səhifə
-
 365. səhifə
365. səhifə
-
 366. səhifə
366. səhifə
-
 367. səhifə
367. səhifə
-
 368. səhifə
368. səhifə
-
 369. səhifə
369. səhifə
-
 370. səhifə
370. səhifə
-
 371. səhifə
371. səhifə
-
 372. səhifə
372. səhifə
-
 373. səhifə
373. səhifə
-
 374. səhifə
374. səhifə
-
 375. səhifə
375. səhifə
-
 376. səhifə
376. səhifə
-
 377. səhifə
377. səhifə
-
 378. səhifə
378. səhifə
-
 379. səhifə
379. səhifə
-
 380. səhifə
380. səhifə
-
 381. səhifə
381. səhifə
-
 382. səhifə
382. səhifə
-
 383. səhifə
383. səhifə
-
 384. səhifə
384. səhifə
-
 385. səhifə
385. səhifə
-
 386. səhifə
386. səhifə
-
 387. səhifə
387. səhifə
-
 388. səhifə
388. səhifə
-
 389. səhifə
389. səhifə
-
 390. səhifə
390. səhifə
-
 391. səhifə
391. səhifə
-
 392. səhifə
392. səhifə
-
 393. səhifə
393. səhifə
-
 394. səhifə
394. səhifə
-
 395. səhifə
395. səhifə
-
 396. səhifə
396. səhifə
-
 397. səhifə
397. səhifə
-
 398. səhifə
398. səhifə
-
 399. səhifə
399. səhifə
-
 400. səhifə
400. səhifə
-
 401. səhifə
401. səhifə
-
 402. səhifə
402. səhifə
-
 403. səhifə
403. səhifə
-
 404. səhifə
404. səhifə
-
 405. səhifə
405. səhifə
-
 406. səhifə
406. səhifə
-
 407. səhifə
407. səhifə
-
 408. səhifə
408. səhifə
-
 409. səhifə
409. səhifə
-
 410. səhifə
410. səhifə
-
 411. səhifə
411. səhifə
-
 412. səhifə
412. səhifə
-
 413. səhifə
413. səhifə
-
 414. səhifə
414. səhifə
-
 415. səhifə
415. səhifə
-
 416. səhifə
416. səhifə
-
 417. səhifə
417. səhifə
-
 418. səhifə
418. səhifə
-
 419. səhifə
419. səhifə
-
 420. səhifə
420. səhifə
-
 421. səhifə
421. səhifə
-
 422. səhifə
422. səhifə
-
 423. səhifə
423. səhifə
-
 424. səhifə
424. səhifə
-
 425. səhifə
425. səhifə
-
 426. səhifə
426. səhifə
-
 427. səhifə
427. səhifə
-
 428. səhifə
428. səhifə
-
 429. səhifə
429. səhifə
-
 430. səhifə
430. səhifə
-
 431. səhifə
431. səhifə
-
 432. səhifə
432. səhifə
-
 433. səhifə
433. səhifə
-
 434. səhifə
434. səhifə
-
 435. səhifə
435. səhifə
-
 436. səhifə
436. səhifə
-
 437. səhifə
437. səhifə
-
 438. səhifə
438. səhifə
-
 439. səhifə
439. səhifə
-
 440. səhifə
440. səhifə
-
 441. səhifə
441. səhifə
-
 442. səhifə
442. səhifə
-
 443. səhifə
443. səhifə
-
 444. səhifə
444. səhifə
-
 445. səhifə
445. səhifə
-
 446. səhifə
446. səhifə
-
 447. səhifə
447. səhifə
-
 448. səhifə
448. səhifə
-
 449. səhifə
449. səhifə
-
 450. səhifə
450. səhifə
-
 451. səhifə
451. səhifə
-
 452. səhifə
452. səhifə
-
 453. səhifə
453. səhifə
-
 454. səhifə
454. səhifə
-
 455. səhifə
455. səhifə
-
 456. səhifə
456. səhifə
-
 457. səhifə
457. səhifə
-
 458. səhifə
458. səhifə
-
 459. səhifə
459. səhifə
-
 460. səhifə
460. səhifə
-
 461. səhifə
461. səhifə
-
 462. səhifə
462. səhifə
-
463. səhifə
463. səhifə
-
 464. səhifə
464. səhifə
-
 465. səhifə
465. səhifə
-
 466. səhifə
466. səhifə
-
 467. səhifə
467. səhifə
-
 468. səhifə
468. səhifə
-
 469. səhifə
469. səhifə
-
 470. səhifə
470. səhifə
-
 471. səhifə
471. səhifə
-
 472. səhifə
472. səhifə
-
 473. səhifə
473. səhifə
-
 474. səhifə
474. səhifə
-
 475. səhifə
475. səhifə
-
 476. səhifə
476. səhifə
-
 477. səhifə
477. səhifə
-
 478. səhifə
478. səhifə
-
 479. səhifə
479. səhifə
-
 480. səhifə
480. səhifə
-
 481. səhifə
481. səhifə
-
 482. səhifə
482. səhifə
-
 483. səhifə
483. səhifə
-
 484. səhifə
484. səhifə
-
 485. səhifə
485. səhifə
-
 486. səhifə
486. səhifə
-
 487. səhifə
487. səhifə
-
 488. səhifə
488. səhifə
-
 489. səhifə
489. səhifə
-
 490. səhifə
490. səhifə
-
 491. səhifə
491. səhifə
-
 492. səhifə
492. səhifə
-
 493. səhifə
493. səhifə
-
 494. səhifə
494. səhifə
-
 495. səhifə
495. səhifə
-
 496. səhifə
496. səhifə
-
 497. səhifə
497. səhifə
-
 498. səhifə
498. səhifə
-
 499. səhifə
499. səhifə
-
 500. səhifə
500. səhifə
-
 501. səhifə
501. səhifə
-
 502. səhifə
502. səhifə
-
 503. səhifə
503. səhifə
-
 504. səhifə
504. səhifə
-
 505. səhifə
505. səhifə
-
 506. səhifə
506. səhifə
-
 507. səhifə
507. səhifə
-
 508. səhifə
508. səhifə
-
 509. səhifə
509. səhifə
-
 510. səhifə
510. səhifə
-
 511. səhifə
511. səhifə
-
 512. səhifə
512. səhifə
-
 513. səhifə
513. səhifə
-
 514. səhifə
514. səhifə
-
 515. səhifə
515. səhifə
-
 516. səhifə
516. səhifə
-
 517. səhifə
517. səhifə
-
 518. səhifə
518. səhifə
-
 519. səhifə
519. səhifə
-
 520. səhifə
520. səhifə
-
 521. səhifə
521. səhifə
-
 522. səhifə
522. səhifə
-
 523. səhifə
523. səhifə
-
 524. səhifə
524. səhifə
-
 525. səhifə
525. səhifə
-
 526. səhifə
526. səhifə
-
 527. səhifə
527. səhifə
-
 528. səhifə
528. səhifə
-
 529. səhifə
529. səhifə
-
 530. səhifə
530. səhifə
-
 531. səhifə
531. səhifə
-
 532. səhifə
532. səhifə
-
 533. səhifə
533. səhifə
-
 534. səhifə
534. səhifə
-
 535. səhifə
535. səhifə
-
 536. səhifə
536. səhifə
-
 537. səhifə
537. səhifə
-
 538. səhifə
538. səhifə
-
 539. səhifə
539. səhifə
-
 540. səhifə
540. səhifə
-
 541. səhifə
541. səhifə
-
 542. səhifə
542. səhifə
-
 543. səhifə
543. səhifə
-
 544. səhifə
544. səhifə
-
 545. səhifə
545. səhifə
-
 546. səhifə
546. səhifə
-
 547. səhifə
547. səhifə
-
 548. səhifə
548. səhifə
-
 549. səhifə
549. səhifə
-
 550. səhifə
550. səhifə
-
 551. səhifə
551. səhifə
-
 552. səhifə
552. səhifə
-
 553. səhifə
553. səhifə
-
 554. səhifə
554. səhifə
-
 555. səhifə
555. səhifə
-
 556. səhifə
556. səhifə
-
 557. səhifə
557. səhifə
-
 558. səhifə
558. səhifə
-
 559. səhifə
559. səhifə
-
 560. səhifə
560. səhifə
-
 561. səhifə
561. səhifə
-
 562. səhifə
562. səhifə
-
 563. səhifə
563. səhifə
-
 564. səhifə
564. səhifə
-
 565. səhifə
565. səhifə
-
 566. səhifə
566. səhifə
-
 567. səhifə
567. səhifə
-
 568. səhifə
568. səhifə
-
 569. səhifə
569. səhifə
-
 570. səhifə
570. səhifə
-
 571. səhifə
571. səhifə
-
 572. səhifə
572. səhifə
-
 573. səhifə
573. səhifə
-
 574. səhifə
574. səhifə
-
 575. səhifə
575. səhifə
-
 576. səhifə
576. səhifə
-
 577. səhifə
577. səhifə
-
 578. səhifə
578. səhifə
-
 579. səhifə
579. səhifə
-
 580. səhifə
580. səhifə
-
 581. səhifə
581. səhifə
-
 582. səhifə
582. səhifə
-
 583. səhifə
583. səhifə
-
 584. səhifə
584. səhifə
-
 585. səhifə
585. səhifə
-
 586. səhifə
586. səhifə
-
 587. səhifə
587. səhifə
-
 588. səhifə
588. səhifə
-
 589. səhifə
589. səhifə
-
 590. səhifə
590. səhifə
-
 591. səhifə
591. səhifə
-
 592. səhifə
592. səhifə
-
 593. səhifə
593. səhifə
-
 594. səhifə
594. səhifə
-
 595. səhifə
595. səhifə
-
 596. səhifə
596. səhifə
-
 597. səhifə
597. səhifə
-
 598. səhifə
598. səhifə
-
 599. səhifə
599. səhifə
-
 600. səhifə
600. səhifə
-
 601. səhifə
601. səhifə
-
 602. səhifə
602. səhifə
-
 603. səhifə
603. səhifə
-
 604. səhifə
604. səhifə
-
 605. səhifə
605. səhifə
-
 606. səhifə
606. səhifə
-
 607. səhifə
607. səhifə
-
 608. səhifə
608. səhifə
-
 609. səhifə
609. səhifə
-
 610. səhifə
610. səhifə
-
 611. səhifə
611. səhifə
-
 612. səhifə
612. səhifə
-
 613. səhifə
613. səhifə
-
 614. səhifə
614. səhifə
Seçilənlər Seçilənlərə əlavə et
Statistika
-
Cəmi səhifə sayısı : 614
-
Baxılan səhifələrin sayısı : Bu funksiyadan istifadə etmək üçün qeydiyyatdan keçməlisiniz.
-
Baxılmamış səhifələrin sayısı : Bu funksiyadan istifadə etmək üçün qeydiyyatdan keçməlisiniz.
Cəmi səhifə 614